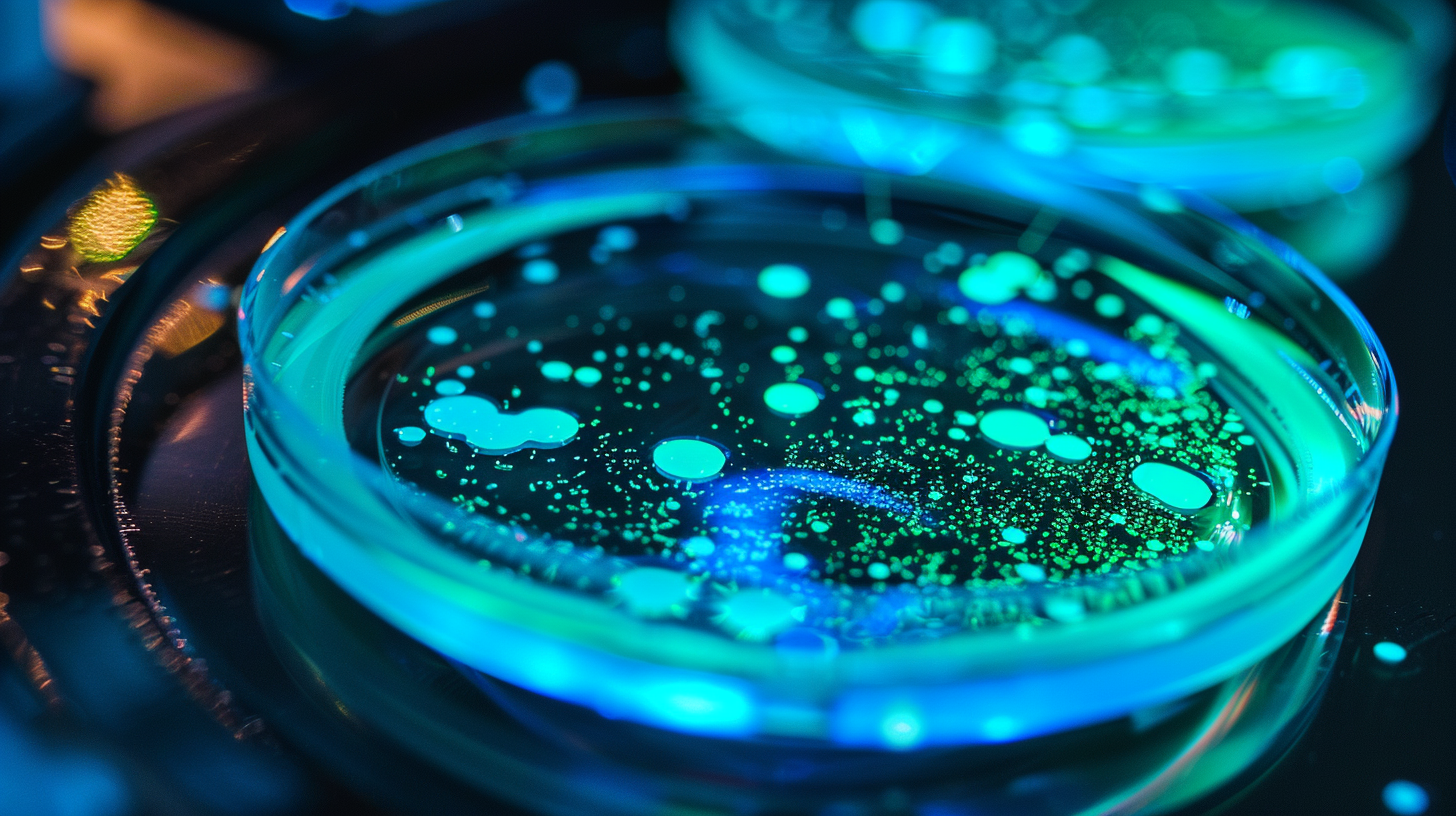
Mycelium Solutions

Engineering Life
for a Sustainable Future
Protogen Bio harnesses the power of synthetic biology to create revolutionary solutions for environmental restoration, from glowing biosensors to extremophile organism research.
Revolutionary Solutions
From environmental monitoring to extremophile research, our biotechnology innovations are shaping the future of sustainable living and ecosystem restoration.

Bioluminescent Biosensors
Revolutionary bacteria that glow in response to contaminants, providing real-time environmental monitoring.

Environmental Remediation
CRISPR-enhanced organisms that clean water, process waste, and restore damaged ecosystems.
Educational Kits
DIY biotechnology kits that make cutting-edge science accessible to students and enthusiasts.
Mycelium Solutions
Engineered fungi for sustainable materials, waste processing, and ecosystem restoration.

Synthetic Biology Platform
Advanced gene editing tools and biological circuits for custom organism development.

Extremophile Research
Collaborating with Mars Technology Institute on organism research for extreme environments.

Bioluminescent Organisms
Custom glowing plants and animals. Proven capability to transform any albino animal into a bioluminescent specimen.
Bioluminescent Organisms in Action
Watch our engineered bioluminescent fungi producing light through natural biological processes.
Advanced Technology
Platform
Our cutting-edge synthetic biology platform combines CRISPR gene editing, metabolic engineering, and bioluminescent reporter systems to create living solutions for environmental challenges.
CRISPR-Cas9 Engineering
Precision gene editing for creating organisms with specific environmental functions
Bioluminescent Circuits
Genetic circuits that produce light in response to specific stimuli
Synthetic Metabolic Pathways
Engineered biological processes for breaking down pollutants
Biocontainment Systems
Safety mechanisms ensuring engineered organisms remain controlled

Visionary Leadership

Tana Kieper
Founder & CEO
A distinguished biotechnology innovator with extensive experience in synthetic biology, CRISPR gene editing, and environmental biotechnology. Educated at the University of Saskatchewan, Tana's vision combines rigorous scientific methodology with entrepreneurial innovation.
"We're not just engineering organisms; we're engineering hope for our planet's future and paving the way for humanity's expansion into the cosmos."
BSc in Biotechnology
University of Saskatchewan graduate
Lab Manager
Ran lab at University of Saskatoon as TA
Research Partnerships
Collaborating with Mars Technology Institute
30+ Years Experience
Horse breeder and instructor expertise
Key Publications
- ▸Engineering Bioluminescent Biosensors for Environmental Monitoring
- ▸CRISPR Applications in Extremophile Organisms
- ▸Synthetic Biology Approaches to Terraforming
- ▸Democratizing Biotechnology Education
Let's Create the Future
Ready to revolutionize environmental restoration or interested in our research collaborations? We'd love to hear from you.
Headquarters
Florida, USA
Biotechnology Innovation Hub
Research Office
Saskatoon, Canada
University Partnership Lab
hello@protogenbio.com
We respond within 24 hours
Phone
+1 639 916 2243
Mon-Fri 9:00 AM - 6:00 PM EST
Partnership Opportunities
Interested in investing or collaborating on groundbreaking biotechnology?
Explore Partnerships